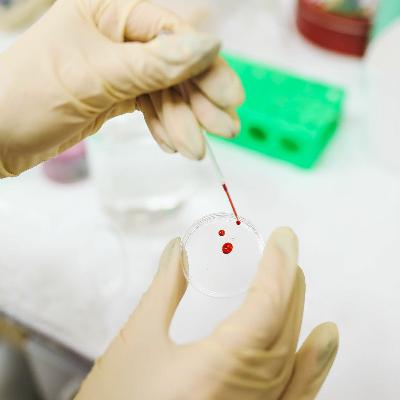

TechNOW: An on-the-spot test to stop overdose deaths
Update: 2021-09-13
Description
The number of Australians who die from unintentional drug overdose continues to rise every year.
Treatment can be complicated because it’s not always known what substance has been taken. And there are new synthetic drugs hitting the streets all the time.
Imagine the benefit of a test that could quickly and accurately identify which drug is present. That's the life-saving tech Professor Shanlin Fu from the University of Technology is making a reality.
TechNOW is a podcast about Australian innovations that are shaping the future, thanks to the Global Connections fund – a project run by the Australian Academy of Technology and Engineering and supported by the Australian Government.
Treatment can be complicated because it’s not always known what substance has been taken. And there are new synthetic drugs hitting the streets all the time.
Imagine the benefit of a test that could quickly and accurately identify which drug is present. That's the life-saving tech Professor Shanlin Fu from the University of Technology is making a reality.
TechNOW is a podcast about Australian innovations that are shaping the future, thanks to the Global Connections fund – a project run by the Australian Academy of Technology and Engineering and supported by the Australian Government.
Comments
In Channel